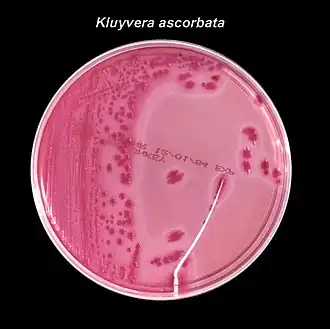
Description de cette image, également commentée ci-après

Kluyvera intermedia
| Domaine | Bacteria |
|---|---|
| Embranchement | Pseudomonadota |
| Classe | Gammaproteobacteria |
| Ordre | Enterobacteriales |
| Famille | Enterobacteriaceae |
| Genre | Kluyvera |
- Enterobacter intermedius corrig. Izard et al., 1980
- Enterobacter intermedium Izard et al., 1980
- Kluyvera cochleae Müller et al., 1996
Kluyvera intermedia est une des espèces du genre bactérien Kluyvera. C'est un bacille à gram négatif de la famille des Enterobacteriaceae qui peut être présent dans les eaux, les sols, les mollusques et les humains.
Description
Kluyvera intermedia est une bactérie anaérobie facultative à Gram négatif et mobiles[1],[3] comme les deux premières espèces du genre Kluyvera[4],[5]. Elle est catalase positive et oxydase negative. Elle peut croître sur milieu de MacConkey, gélose sang et gélose nutritive[3]. Elles forment des colonies grises circulaires, convexes et lisses de 1 à 2 mm de diamètre après un jour de culture et jusqu'à 3 mm après deux jours[3]. Elles peuvent fermenter le D-glucose ainsi que d'autres sucres. Sa croissance est possible entre les températures de 30 °C et 42 °C[3]. Une combinaison de tests biochimiques est nécessaire pour la différencier des K. cryocrescens, K. ascorbata et Kluyvera georgiana[3]. Les réactions biochimiques aux 3-phenylpropionate et m-coumarate permettent de la différencier de l'espèce K. georgiana[3].
Habitat
Kluyvera intermedia a été isolée à partir de eaux de surface, les sols, les mollusques et ldifférents d'échantillons humains[1],[3],[6].
Taxonomie
Étymologie
L'étymologie de cette espèce bactérienne est la suivante : pour le nom de genre Kluy’ver.a. N.L. fem. n. Kluyvera nommées ainsi par Asai et al. (1956) pour honorer le microbiologiste hollandais Albert J. Kluyver[7] et pour l'épithète de l'espèce in.ter.me’di.a. L. fem. adj. intermedia signifiant entre[2],[8].
Historique
Kluyvera intermedia a d'abord été décrite comme Enterobacter intermedium puis corrigé en Enterobacter intermedius en 1980)[1]. En , Müller décrit l'espèce Kluyvera cochleae qu'il différencie de Kluyvera georgiana et des deux premières espèces du genre, K. ascorbata et K. cryocrescens[3]. En , une nouvelle étude phylogénique montre que les Enterobacter intermedius et les Kluyvera cochleae font partie du genre Kluyvera et ne sont qu'une seule et même espèce dénommée alors Kluyvera intermedia[2]. Comme les autres Kluyvera, elle fait partie de la famille des Enterobacteriaceae[8]. La souche type de l'espèce K. intermedia, ATCC 33110 (=CIP 79.27=LMG 2785=CCUG 14183) est l'ancienne souche type d'E. intermedius[2]. Les Kluyvera intermedia peuvent être isolées de Mollusques, d'eaux de surface, de sols et d'échantillons humains[3],[8].
Références
- 1 2 3 4 (en) D Izard, F Gavini et H. Leclerc, « Polynucleotide sequence relatedness and genome size among Enterobacter intermedium sp. nov. and the species Enterobacter cloacae and Klebsiella pneumoniae. », Zentralbl. Bakteriol. Parasitenkd. Infektionskr. Hyg. Abt. 1 Orig. Reihe C, vol. 1, , p. 51-60.
- 1 2 3 4 (en) María E. Pavan, Raúl J. Franco, Juan M. Rodriguez, Patricia Gadaleta, Sharon L. Abbott, J. Michael Janda et Jorge Zorzópulos, « Phylogenetic relationships of the genus Kluyvera: transfer of Enterobacter intermedius Izard et al. 1980 to the genus Kluyvera as Kluyvera intermedia comb. nov. and reclassification of Kluyvera cochleae as a later synonym of K. intermedia », International Journal of Systematic and Evolutionnary Microbiology, vol. 55, no 1, , p. 437-442 (DOI 10.1099/ijs.0.63071-0)
- 1 2 3 4 5 6 7 8 9 (en) Hans E. Müller, Don J. Brenner, G. Richard Fanning, Patrick A. D. Grimont et Peter Kämpfer, « Emended Description of Buttiauxella agrestis with Recognition of Six New Species of Buttiauxella and Two New Species of Kluyvera: Buttiauxella ferragutiae sp. nov., Buttiauxella gaviniae sp. nov., Buttiauxella brennerae sp. nov., Buttiauxella izardii sp. nov., Buttiauxella noackiae sp. nov., Buttiauxella warmboldiae sp. nov., Kluyvera cochleae sp. nov., and Kluyvera georgiana sp. nov. », International Journal of Systematic Bacteriology, (DOI 10.1099/00207713-46-1-50, lire en ligne, consulté le )
- ↑ (en) JJ Farmer, GR Fanning, GP Huntley-Carter, B Holmes, FW Hickman, C Richard et DJ Brenner, « Kluyvera, a new (redefined) genus in the family Enterobacteriaceae: identification of Kluyvera ascorbata sp. nov. and Kluyvera cryocrescens sp. nov. in clinical specimens », J Clin Microbiol, vol. 13, no 5, , p. 919-933 (PMID 7240403, DOI 10.1128/jcm.13.5.919-933.1981)
- ↑ (en) J.j. Farmer, Bergey's Manual of Systematics of Archaea and Bacteria, John Wiley & Sons, Ltd, , 1–18 p. (DOI 10.1002/9781118960608.gbm01151), « Kluyvera »
- ↑ Prober, Principles and practice of pediatric infectious diseases, Edinburgh, Elsevier Saunders, (ISBN 1-4557-3985-5)
- ↑ (en) « Genus Kluyvera », sur LPSN - List of Prokaryotic names with Standing in Nomenclature (consulté le )
- 1 2 3 (en) « Species Kluyvera intermedia », sur LPSN - List of Prokaryotic names with Standing in Nomenclature (consulté le )
Annexes
Bibliographie
- Don J. Brenner, Noel R. Krieg, James T. Staley, George M. Garrity, David R. Boone, Paul De Vos, Michael Goodfellow, Fred A. Rainey et Karl-Heinz Schleifer, Bergey's Manual of Systematic Bacteriology, vol. 2 : Part B The Gammaproteobacteria, Boston, Springer, , 304 p. (ISBN 9780387280226).
Articles connexes
Liens externes
- Ressources relatives au vivant :
- Portail de la microbiologie